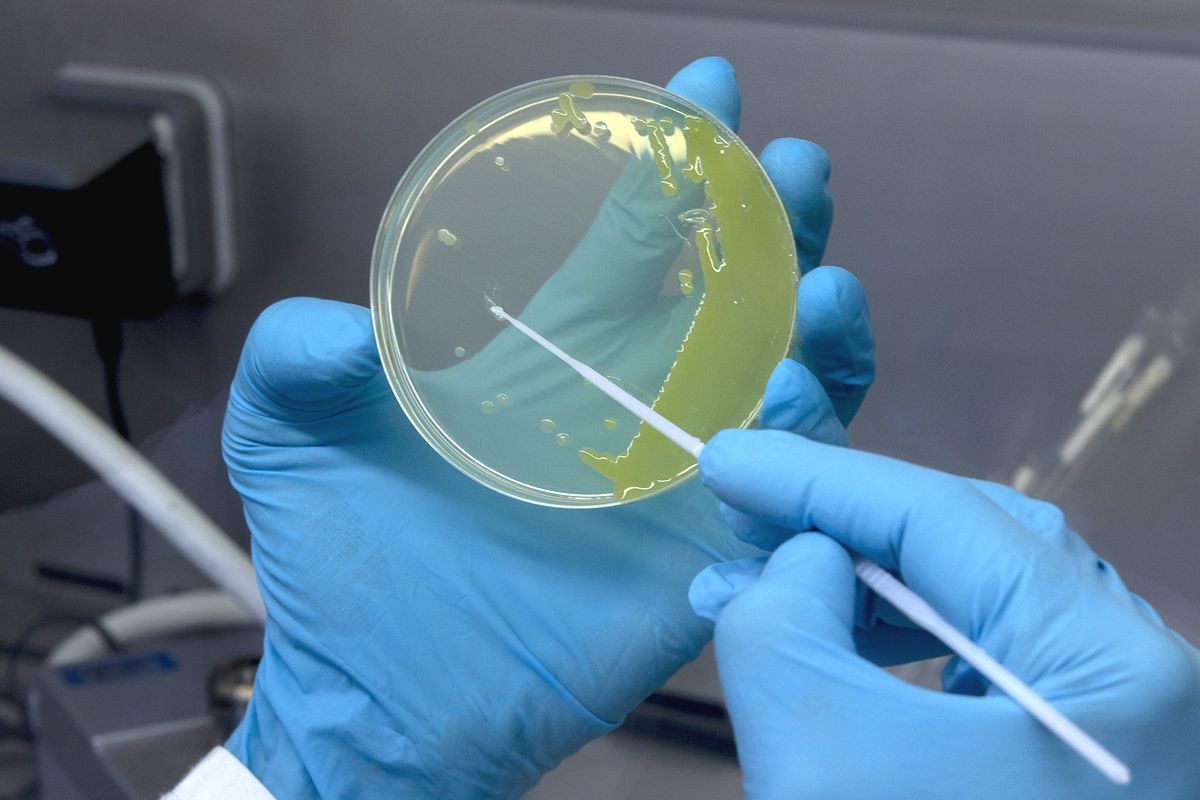

- Enseignant: Hiba NAAS

Le module d'immunologie appliquée crée un pont entre les concepts fondamentaux et leur mise en pratique diagnostique et thérapeutique. Il se focalise sur trois axes principaux : l'exploitation des réactions antigène-anticorps, les stratégies de modulation immunitaire (vaccination, sérothérapie) et l'analyse des dysfonctionnements du système immunitaire.
- Enseignant: Samia ALIANE
LES EXERCICES SUR LA MICROBIOLOGIE GLE POUR MIEUX COMPRENDRE CE DOMAINE
- Enseignant: Mhamed BENADA

The main objective of microbiology is to study the properties of microorganisms that surround us everywhere—in water, soil, and in human and animal organisms. This study aims to exploit the properties of microorganisms that are beneficial to humans in various sectors of the economy, as well as to understand microorganisms that cause human and animal diseases, in order to develop specific therapies and prevent infectious diseases.
This document, entitled “General Microbiology,” is intended for second-year students in Food Sciences. Its objective is to provide fundamental knowledge in this field, beginning with the evolution of microbiology, the classification of living organisms, and how bacteria came to be recognized as a distinct kingdom.
It also addresses the different relationships that exist between the host and the microorganism, the general structure of the bacterial cell, its modes of nutrition and growth, as well as methods for controlling bacteria, with particular emphasis on antibiotics.
Finally, this document introduces the field of mycology, that is, the study of fungi, and concludes with a brief overview of the viral world.
- Enseignant: Mhamed BENADA

Introduction to the basic definitions of food and the multitude of food groups, as well as the degrees and processes of transformation. Upon completion of this course, students will be able to differentiate between food groups and understand their characteristics, as well as the basics of their production and the processing of agricultural raw materials.
- Enseignant: Zouheyr HADRI